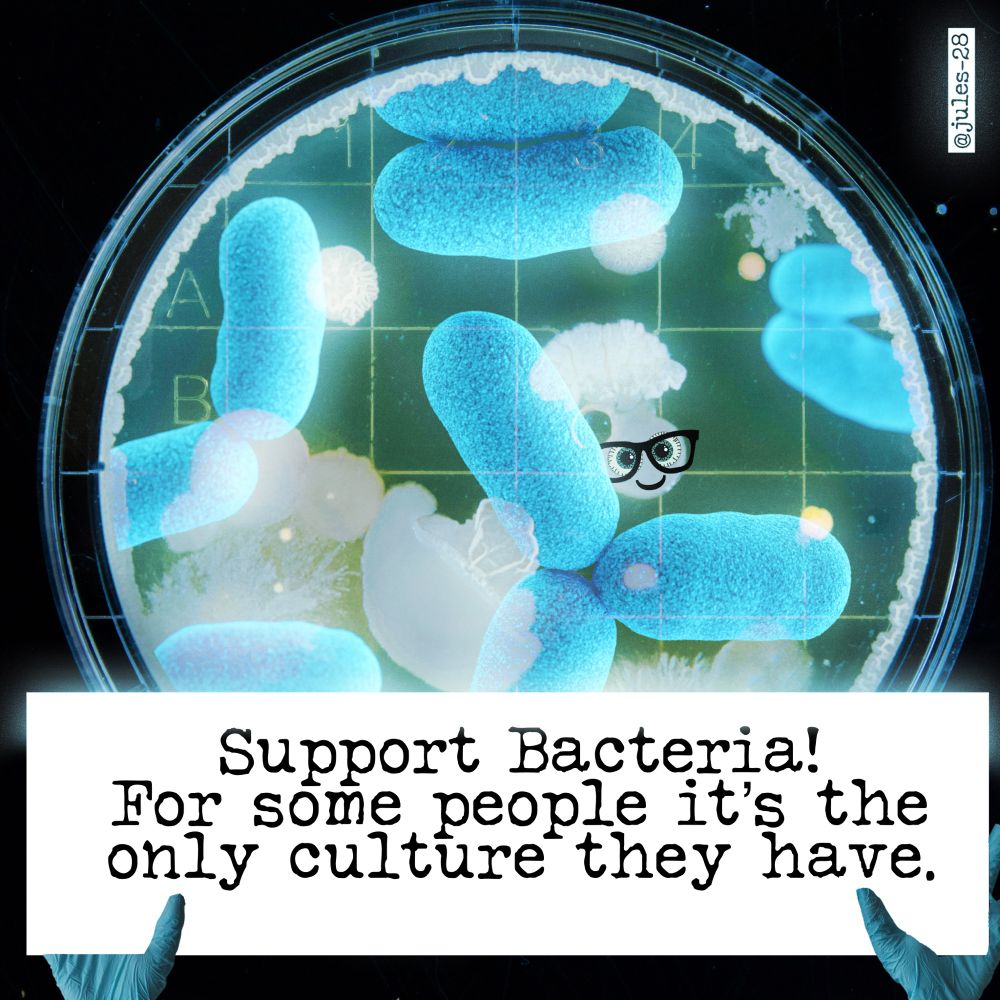
Post image

23.12.2025 17:01 —
👍 0
🔁 0
💬 0
📌 0
23.12.2025 17:01 —
👍 0
🔁 0
💬 0
📌 0
Yep, there is something cute about them. But not howling in a pack for hours!
30.10.2025 08:34 —
👍 1
🔁 0
💬 1
📌 0
🤞🏼🤞🏼🤞🏼 for the series! Detroit supports the Jays!!!
26.10.2025 15:14 —
👍 1
🔁 0
💬 0
📌 0
 26.10.2025 15:13 —
👍 0
🔁 0
💬 0
📌 0
26.10.2025 15:13 —
👍 0
🔁 0
💬 0
📌 0
And here in my world the coyotes were so loud I had to turn on a loud sound machine to drown out the noise all night.
26.10.2025 14:53 —
👍 1
🔁 0
💬 1
📌 0
 28.06.2025 22:10 —
👍 4
🔁 1
💬 1
📌 0
28.06.2025 22:10 —
👍 4
🔁 1
💬 1
📌 0

Please. Enough.
28.06.2025 19:46 —
👍 4
🔁 0
💬 0
📌 0

Happy Mothers Day to all. It’s not always easy but it’s always worth it. ❤️
11.05.2025 16:40 —
👍 2
🔁 0
💬 0
📌 0

#CincoDeMayo
05.05.2025 17:38 —
👍 3
🔁 1
💬 0
📌 0

Detroit #MayDay
01.05.2025 20:36 —
👍 47
🔁 11
💬 2
📌 0

Democracy Defenders, Buster and Bette, ready to lend a paw at today’s #MayDay event at Detroit’s train station.
01.05.2025 20:24 —
👍 4
🔁 0
💬 0
📌 0

My Michigan 10th District, missing-in-action brainless rep, John James, on his whoring quest to be governor found his stooge brothers to party with.
#Leadership
01.05.2025 17:45 —
👍 5
🔁 0
💬 0
📌 0

I thought this was the Secretary of State’s job. I guess now the Sec of Defense is running our foreign policy using tweet threats.
01.05.2025 00:55 —
👍 7901
🔁 1961
💬 1725
📌 376
 01.05.2025 04:27 —
👍 1533
🔁 399
💬 23
📌 16
01.05.2025 04:27 —
👍 1533
🔁 399
💬 23
📌 16

Great sign at yesterday’s Warren, Michigan protest
30.04.2025 23:43 —
👍 6
🔁 2
💬 0
📌 0

Hey @jimacosta.bsky.social you were featured on a protest sign here in Michigan yesterday!
30.04.2025 23:42 —
👍 4
🔁 0
💬 0
📌 0

🤣🦅🤣
29.04.2025 22:53 —
👍 36198
🔁 4978
💬 1023
📌 381
5X her pay!
24.04.2025 02:48 —
👍 7
🔁 3
💬 1
📌 0
On it.
30.04.2025 06:10 —
👍 1
🔁 0
💬 0
📌 1

Let's go Michigan!
@patawan1.substack.com
@jules-28.bsky.social
@coachstreit75.bsky.social
@mlipsitt.bsky.social
@japulver.bsky.social
@laury24.bsky.social
@bocksam.bsky.social
@sherilane.bsky.social
@charlesgaba.com
@christine414.bsky.social
@bluecoatarmy.bsky.social
Share with friends & fam!
28.04.2025 18:07 —
👍 20
🔁 11
💬 1
📌 1

On my way to greet our corrupt, lying piece of crap president today.
29.04.2025 18:30 —
👍 3
🔁 0
💬 0
📌 0

Good Folks 2 Follow
@hellesbellz.bsky.social
@nursedeb007.bsky.social
@hilary-grant3362.bsky.social
@chongintommy1.bsky.social
@rljennings.bsky.social
@kirklander1949.bsky.social
@burntundertones.bsky.social
@bandrol.bsky.social
@mickeyfinn123.bsky.social
@nealevon.bsky.social
@gdad1x7.bsky.social
24.04.2025 19:35 —
👍 66
🔁 21
💬 14
📌 6

You can thank me later.
24.04.2025 20:57 —
👍 0
🔁 0
💬 0
📌 0

#Science
24.04.2025 15:47 —
👍 1
🔁 0
💬 0
📌 0
A federal judge ordered the Trump administration to restore funding for Voice of America (VOA), an international news service created by Congress.
VOA was founded during World War II to counter Nazi propaganda.
No wonder the GOP wants it dismantled.
22.04.2025 23:49 —
👍 95
🔁 32
💬 3
📌 1

They had lawyers, trials, most were given pretrial release, allowed to testify in their own defense, got discovery, could call witnesses, could cross-examine witnesses, could present mitigation at sentencing, and had a right to appeal.
21.04.2025 16:00 —
👍 37444
🔁 9634
💬 3377
📌 1059
Like I said months ago was their main goal
21.04.2025 15:34 —
👍 886
🔁 225
💬 58
📌 8
For Dr. Phil, too! 🤮
20.04.2025 05:44 —
👍 3
🔁 0
💬 0
📌 0
 23.12.2025 17:01 —
👍 0
🔁 0
💬 0
📌 0
23.12.2025 17:01 —
👍 0
🔁 0
💬 0
📌 0
 26.10.2025 15:13 —
👍 0
🔁 0
💬 0
📌 0
26.10.2025 15:13 —
👍 0
🔁 0
💬 0
📌 0
 28.06.2025 22:10 —
👍 4
🔁 1
💬 1
📌 0
28.06.2025 22:10 —
👍 4
🔁 1
💬 1
📌 0







 01.05.2025 04:27 —
👍 1533
🔁 399
💬 23
📌 16
01.05.2025 04:27 —
👍 1533
🔁 399
💬 23
📌 16